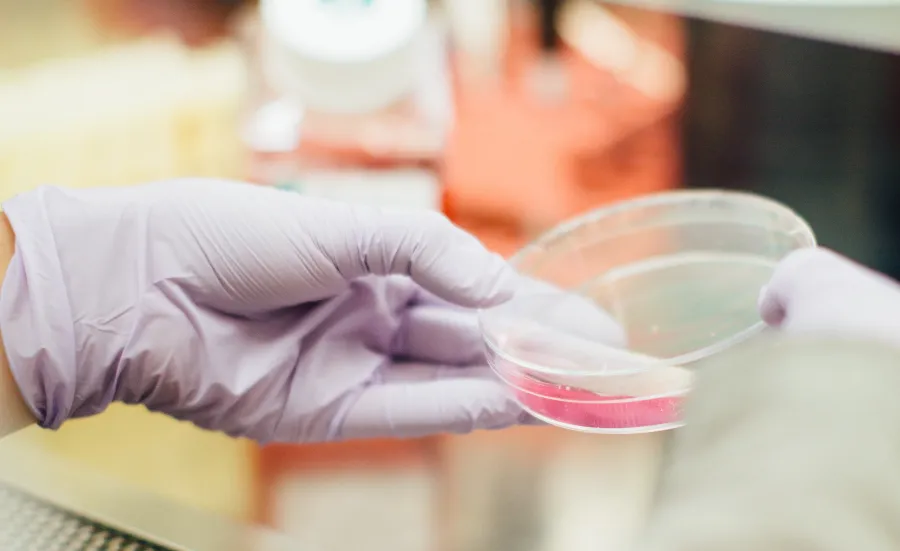
Stock image of a researcher's gloved hand holding a small circular glass container with a pink substance inside.

Large biomolecular drugs, known as biologics, are commonly used to treat human diseases including cancer and autoimmune disorders. They make up half of the top 10 blockbuster pharmaceutical products and gross around $30 billion per year globally.
80% of these biologics are monoclonal antibodies (mAb), and our researchers have played a significant role in bringing 2 of these from the lab to the clinic.
Ofatumumab (trade name Arzerra) and Obinutuzumab (trade name Gazyva) are now used to treat the B cell disorders: chronic lymphotic leukaemia and follicular lymphoma.
History
2002
Professors Martin Glennie and Mark Cragg discovered 2 distinct types of CD20 antibodies, which went on to shape the pharmaceutical industry's development of a new generation of drugs to target B cells for treating blood cancers.
2004
Professor Glennie joined Danish biotech firm Genmab for a 6-month sabbatical, during which he led a small research team that developed a next generation CD20 mAb capable of replacing its predecessor: rituximab.
Martin's team went on to create and patent ofatumumab which, unlike rituximab, is a fully human antibody and also more potent.
Both professors also worked alongside Professor Stephen Beers to explore the relative potency of Type I and II mAbs, which in turn helped support the development of a 3rd generation mAb: obinutuzumab.
Clinical and commercial impact
Ofatumumab (Arzerra)
Ofatumumab was approved by the Federal Drug Administration (FDA) in 2009, and the European Union in 2011, for treatment of the most prevalent form of leukaemia: chronic lymphocytic leukaemia (CLL). Southampton researchers proved that it was able to kill target cells that had previously been resistant to similar drugs.
In 2016, it was approved by the FDA as a treatment for recurrent, progressive and relapsed CLL, in combination with Fludarabine and Cyclophosphamide.
Its ability to delete B cells has been assessed in autoimmune conditions such as rheumatoid arthritis, which affects more than 400 million patients worldwide, and multiple sclerosis, which affects over 2 million.
Ofatumumab has achieved sales revenues of more than $200 million since 2013, translating to £40 million in royalties for Genmab. GlaxoSmithKline's rights to its use in cancer were acquired by Novartis in August 2015, in a deal worth up to $1 billion.
Obinutuzumab (Gazyva)
Obinutuzumab was FDA-approved for CLL in November 2013, and follicular lymphoma in November 2017, with positive results for frontline clinical treatment in both cases. It has also been assessed in clinical trials for post-transplant lymphoproliferative disorder and renal disease. In addition, the FDA granted it Breakthrough Therapy Designation for adults with lupus nephritis.
Sales of the biologic drug have grown year-on-year since FDA approval in November 2013, reaching over £500 million in 2020.